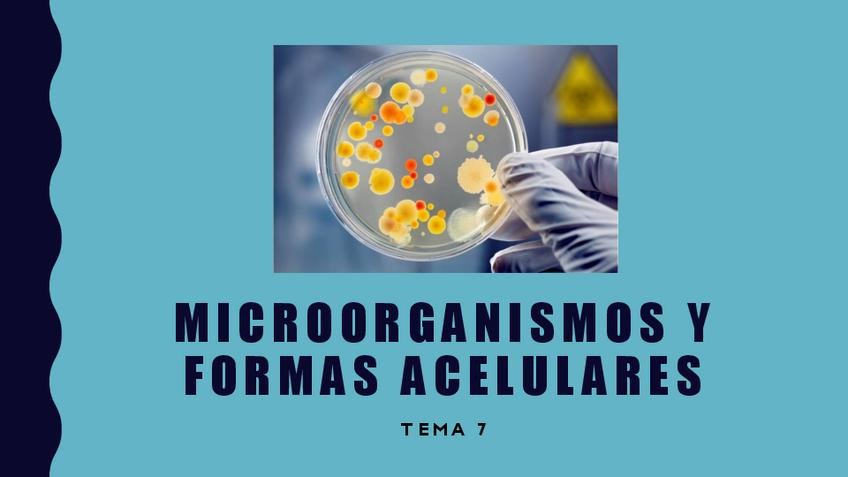

@dani_19
Bio: Estudiante de 2º Bachillerato con enfoque a la PAU Madrid 2026. Asignaturas que estoy cursando: Lengua Castellana y Literatura, Matemáticas II, Inglés, Alemán, Biología, Química, Historia de España y de la Filosofía. Cualquier duda, estaré encantado de ayudaros.
86 Publicaciones
238 Interacciones
2 Seguidores
0 Siguiendo
Lista de publicaciones de dani_19
La poesía de la generación del 27: características y trayectoria poética de los poetas del 27. El teatro lorquiano
La poesía de la generación del 27 características y trayectoria poética de los poetas del 27. El teatro lorquiano
Resumen de genética molecular de 2ºBachillerato: replicación, transcripción, traducción, mutaciones...